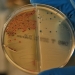

En relativamente muy poco tiempo, el concepto de ‘digitalización’ ha pasado a adquirir más notoriedad que nunca. Adaptarnos a la situación que atravesamos sanitaria, social y económica ha requerido sin duda una evolución en este sentido por parte de empresas, administración y sociedad. Sin embargo, también ha puesto de manifiesto que aquellos que avanzaron en este proceso de transformación digital, desde mucho antes de la llegada de la pandemia, estaban más preparados.
Gestionar el ciclo integral del agua en los más de 90 municipios donde opera Hidraqua y sus empresas participadas en la Comunitat Valenciana es el gran reto en nuestra gestión. La llegada del COVID19 nos obligó en un corto período de tiempo a adaptar nuestros procesos para conseguir dos retos fundamentales: velar por la seguridad y salud de nuestra plantilla y garantizar un servicio esencial a más de dos millones de ciudadanos y ciudadanas. Con esta filosofía y con este afán es con el que hemos trabajado desde siempre, y con más ímpetu si es posible, durante los momentos que atravesamos. Sin embargo, cualquier esfuerzo hubiera sido en vano si esta transformación digital no hubiera nacido años atrás en nuestra organización y en el grupo al que pertenecemos, la multinacional SUEZ, presente en los cinco continentes y con más de 89.000 empleados y empleadas.
Por eso hoy destacamos ‘Hidraqua, el valor social de la digitalización. 50 experiencias reales de un proceso de transformación’. Una iniciativa que pretende poner en valor a lo largo de 2021 cómo la digitalización no es algo novedoso para nosotros, sino una estrategia en la que llevamos años trabajando, y que ha marcado y marca la diferencia de nuestra gestión dentro del sector del agua y el medio ambiente. Cabe destacar además que cumplimos 50 años en la Comunitat, un hito que hemos querido celebrar a través de esta acción.
A través de 50 entrevistas se reflejará cómo la digitalización nos ha llevado a mejorar, a controlar en tiempo real todas nuestras operaciones, a ser más inteligentes en la toma de decisiones, a ofrecer un servicio excelente al cliente y a las ciudades, a ser más ágiles y eficientes. Desde todas las áreas de la empresa y a todos los niveles. Todo el contenido de estas entrevistas que se irán publicando semanalmente estará disponible en la web www.hidraqua.es.
Son las historias de vida, trabajo, tesón, experiencia, conocimiento y esfuerzo de nuestro principal activo, nuestra plantilla. Los profesionales que desarrollan, adaptan y gestionan las soluciones innovadoras que nos permiten responder a las necesidades de cada municipio los 365 días del año.
Sin embargo, el proceso de digitalización no acaba aquí. Nos encontramos en el punto clave para conseguir la tan ansiada por la Unión Europea ‘recuperación digital y sostenible’, en la que administración y empresa, a través de alianzas, participemos de forma conjunta y coordinada para afrontar los grandes retos mundiales como la superación de esta crisis o la necesidad de cumplir con los Objetivos de Desarrollo Sostenible de la ONU marcados dentro de la agenda 2030.
En Hidraqua y sus empresas participadas -Aguas de Alicante, Aigües d’Elx, AGAMED, Aigües de l’Horta, Aigües de Paterna y Aigües de Cullera-, vamos a trabajar con este fin. Con el propósito de apoyar a los municipios en esta recuperación económica, a través del Pacto Social que estamos impulsando en varios de los que operamos y que seguiremos extendiendo a otras muchas localidades a lo largo de 2021. Un pacto que apueste por una recuperación verde y sostenible que ponga en el centro de nuestra gestión a las personas.
Pero en el que además podamos, a través de la digitalización, seguir aportando valor. Herramientas como la plataforma City Sentinel nos ayuda a anticiparnos a la evolución de la pandemia y a seguir garantizando un servicio de calidad para todos los ciudadanos. Y, una vez los momentos más duros se hayan superado, desarrollaremos soluciones con las que, a través del análisis de los consumos de agua, podamos conocer la evolución económica en cada territorio. Y cuando llegue el momento de reconstruir, ofreceremos todo nuestro valor y experiencia para contribuir a los planes de municipio y territorio que se definan por parte de las administraciones competentes.
Invertir en infraestructuras capaces de afrontar las consecuencias del cambio climático, contribuir al turismo sostenible y responsable, la modernización de los sistemas, la preservación de los espacios naturales y el uso responsable de los recursos; pasan en un momento u otro por la gestión del agua y por este conocimiento y bagaje en el ámbito de la digitalización.
La pandemia nos ha demostrado que estamos preparados para esta evolución y contribuir activamente a la ‘reconstrucción verde’, y es el momento de pasar a la acción, utilizando todas las herramientas, datos con los que contamos, conocimiento y capacidad que hemos adquirido en las últimas cinco décadas para participar, a través de la gestión del agua, en una recuperación sostenible, digital y resiliente. Pensada siempre por y para las personas.